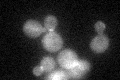
YOR188W
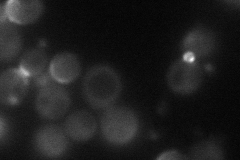
YOR188W
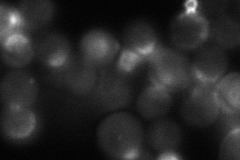
YOR188W
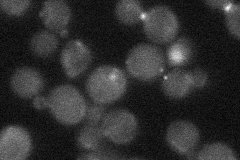
YOR188W
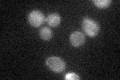
YOR188W

View description
Protein involved in positive regulation of both 1,3-beta-glucan synthesis and the Pkc1p-MAPK pathway, potential Cdc28p substrate; multicopy suppressor of temperature-sensitive mutations in CDC24 and CDC42, and of mutations in BEM4
Localization:
Intensity:
Fold change:
Significance:
-
C’ GFP library in SD
bud neck:cytosolN/A -
N' NOP1pr-GFP in SD
bud50.6168 -
N' TEF2pr-mCherry in SD
bud neck44.4722 -
N' NATIVEpr-GFP in SD
bud neck25.6245 -
N' TEF2pr-VC and Cyto-VN in SD

bud neck35.0174 -
C’ GFP library in SD+DTT

bud neck.cytosol21.910.78No -
C’ GFP library in SD+H2O2
bud neck.cytosol29.381.05No -
C’ GFP library in Starvation Media

bud neck,cytosol18.560.66Yes -
C’ GFP library on the background of Pup2-DaMP

bud neck:cytosol -
C’ GFP library on the background of CCT mutant

bud neck:cytosol30.71961.1026No
